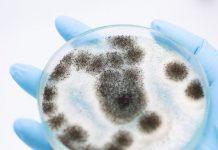
Alergia al moho: causas, síntomas, tratamiento y prevención Alergia al moho: causas, síntomas, tratamiento y prevención

Todo sobre los dispositivos pulmonares (nebulizadores e inhaladores) y cómo se utilizan en el tratamiento adecuado de la rinitis alérgica.
El tratamiento para la rinitis alérgica siempre está evolucionando, con nuevas opciones disponibles todo el tiempo. Aunque tradicionalmente, las mejores opciones fueron los antihistamínicos, los corticosteroides en aerosol nasales y la inmunoterapia mediante inyecciones para la alergia, el uso de otros dispositivos, a menudo empleados para reducir o controlar los síntomas del asma, también son opciones viables para el tratamiento.
Los dispositivos pulmonares (nebulizadores e inhaladores) en el tratamiento de la rinitis alérgica no son una idea novedosa, pero se han convertido en una opción considerada con frecuencia. Si bien estos han sido empleados durante mucho tiempo para pacientes con asma, enfisema y otras afecciones pulmonares severas. ¿Cuáles son las perspectivas de usar un dispositivo pulmonar para tratar las alergias estacionales (fiebre del heno)?

Contenidos
- 1 ¿Qué es un nebulizador?
- 2 Inhaladores
- 3 Rinitis alérgica
- 4 Causas
- 5 Los síntomas
- 6 Tratamientos estandar
- 7 Conclusión
¿Qué es un nebulizador?
Un nebulizador, a veces llamado máquina de respiración, se usa para tomar un medicamento líquido y convertirlo en un rocío fino que se puede inhalar. Si bien hay varios medicamentos disponibles para su uso de esta manera, el más comúnmente prescrito en el Albuterol, que también ha sido un tratamiento muy popular para el asma en forma de inhalador.
También conocidos como “tratamientos respiratorios”, los nebulizadores son fáciles de usar. Inserte el medicamento en la máquina, coloque la boquilla en la boca y presione el interruptor para encender el nebulizador. Inhale y exhale normalmente, y la máquina normalmente se apagará en aproximadamente diez minutos, cuando el medicamento se haya agotado.
Los nebulizadores se usan comúnmente para tratar las sibilancias y la opresión en el pecho para las personas con asma, y se pueden regular fácilmente, lo que le da una ventaja sobre los inhaladores. Los tratamientos regulares en horarios regulados, con dosis específicas, ayudan mucho a reducir las reacciones alérgicas y los síntomas del asma.
Leer ahora > Bronquitis crónica e inhaladores: ¿podría beneficiarse del Symbicort Turbuhaler?Una de las cosas negativas de los nebulizadores es que pueden tener algunos efectos secundarios difíciles de enfrentar.
Algunos de ellos incluyen:
- Aumento de la frecuencia cardíaca.
- Temblores
- Aumento de la presión arterial
Si bien todo esto tiende a ser temporal, puede durar desde unos pocos minutos hasta un par de horas después del tratamiento, pueden ser lo suficientemente severos para que sea más atractivo usar un inhalador, que no afecta tanto a los pacientes.
Inhaladores
Inhaladores y nebulizadores no son lo mismo, aunque la fuerza del tratamiento es igual. No hay una diferencia en la dosificación prevista, pero es más difícil de coordinar debido a una dosificación ligeramente inconsistente. Sin embargo, el uso de un inhalador con un dispositivo espaciador ayuda a resolver este problema, lo que hace que un inhalador sea más conveniente.
Un inhalador es fácil de transportar, y el tamaño pequeño significa que cabe fácilmente en un bolso o bolsillo, a diferencia de un nebulizador. Y para uso de emergencia, esto es vital para que nunca haya una preocupación por no tener un tratamiento disponible cuando ocurre un ataque de asma o alergias graves.
Además, a diferencia de un nebulizador, los inhaladores tardan mucho menos tiempo en usarse. A diferencia de dedicar al menos diez minutos al tratamiento, un inhalador (también conocido como MDI) toma solo unos treinta segundos. Tienden a ser mucho menos costosos que los nebulizadores, causan menos efectos secundarios y crean una forma más fácil de tratar los síntomas de la rinitis alérgica, similar a su uso para el asma.
Leer ahora > Cómo tratan los médicos la alergia al polen: nueve medicamentos que alivian la rinitis alérgica (fiebre del heno)Rinitis alérgica
Para aquellos que no están familiarizados con el término “rinitis alérgica”, los términos “fiebre del heno” y “alergias estacionales” podrían sonar como una campana. La fiebre del heno, como suele llamarse, puede causar muchos síntomas de alergia similares al asma, y en algunos casos, puede ser igual de debilitante.
Causas
Las alergias estacionales son causadas con mayor frecuencia por una variedad de pólenes, con los pastos en la parte superior de la lista, seguidos por los árboles y las malas hierbas. Una reacción alérgica ocurre cuando la histamina producida por el cuerpo para controlar y eliminar el alérgeno de la nariz, las fosas nasales y los pulmones se ve como un atacante por parte del sistema inmunológico. En este caso, se producen anticuerpos para combatir la histamina, lo que lleva a la producción de exceso de moco, inflamación y exceso de líquido.
Los síntomas
Los síntomas de la rinitis alérgica generalmente vienen en paquetes que pueden incluir varios o todos estos:
- Goteo nasal, estornudos y goteo posnasal.
- Prurito e irritación de nariz, garganta, senos y pulmones.
- Tos y, en asmáticos, sibilancias.
- Picazón e irritación de la piel.
- Inflamación y congestión.
Tratamientos estandar
Cuando se trata de tratar las alergias estacionales, hay varias opciones típicas que se emplean, ya sea de venta libre o por prescripción. Los médicos tienden a recomendar comenzando con:
- Antihistamínicos (disponibles en forma de tabletas, líquidos o aerosoles nasales).
- Descongestionantes (solo para uso a corto plazo).
- Corticosteroides nasales (generalmente el método más efectivo).
- Corticosteroides orales (para quienes no pueden tolerar los aerosoles nasales).
- Vacunas para alergias (una forma de inmunoterapia).
- Limpiando las fosas nasales con una solución salina.
Sin embargo, estas opciones no siempre funcionan tan bien como es necesario, o los síntomas son graves y limitan la vida, los dispositivos pulmonares son una excelente alternativa. Han demostrado ser muy prometedores con el asma y, a veces, los síntomas de la rinitis alérgica son muy similares y severos. Por lo tanto, los médicos han recurrido a tratar a los pacientes que sufren más de una leve alergia estacional de la misma manera que tratarían a un asmático, lo que les ha dado a los pacientes nuevas esperanzas y un gran alivio.
Leer ahora > El control de los síntomas de la rinitis alérgicaConclusión
Los dispositivos pulmonares han sido un modo de espera, probado y verdadero, durante mucho tiempo en el tratamiento del asma, pero pasar al reino de la rinitis alérgica es un propósito relativamente nuevo para estos tratamientos. Sin embargo, han sido bastante prometedores para mejorar la calidad de vida de las personas con reacciones severas de fiebre del heno y, especialmente, de las alergias estacionales asociadas al asma.
Podría tener sentido probar los medicamentos más comunes, tanto de venta libre como con receta, antes de esperar que un médico le recete un inhalador o un nebulizador. Ambos dispositivos pueden ayudar a controlar los síntomas de la rinitis alérgica, y la elección depende de si se necesita un tratamiento más estructurado o si es preferible la conveniencia de un inhalador, así como el menor costo. De cualquier manera, la vida puede mejorar, incluso si el paciente tiene reacciones extremas a alergenos específicos.
Hablar con un médico puede ayudarlo a comprender cómo funcionan los inhaladores y los nebulizadores y si son o no las mejores opciones en su situación.
Dispositivos pulmonares (nebulizadores e inhaladores) en el tratamiento de la rinitis alérgica was last modified: marzo 25th, 2019 by Equipo de redacción- Etiquetas
- Dispositivos pulmonares
- inhaladores
- nebulizadores
- rinitis alérgica
Artículos relacionadosMás del autor

5 Cosas que necesitas saber sobre la alergia a las cucarachas
Alergia al moho: causas, síntomas, tratamiento y prevención

Alergia al látex: causas, síntomas, tratamiento y prevención

Cómo tratan los médicos la alergia al polen: nueve medicamentos que alivian la rinitis alérgica (fiebre del heno)

